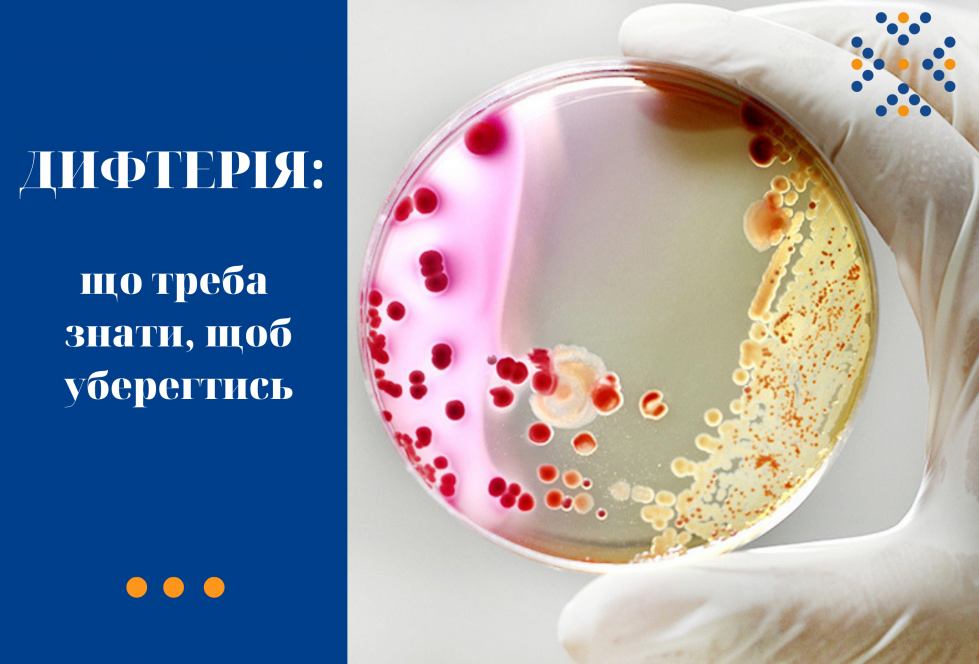
Дифтерія: що треба знати, щоб уберегтись

КРОК У БОРОТЬБІ З ВІЛ В УКРАЇНІ
ДУ "Центр громадського здоров'я МОЗ України" розроблено інтерактивну мапу закладів охорони здоров’я, що надають послуги ВІЛ в Україні. Мета - забезпечити зручний доступ громадян країни до геопросторової інформації щодо закладів охорони здоров’я, які надають послуги з тестування на ВІЛ-інфекцію, доконтактної та постконтактної профілактики, а також забезпечення антиретровірусними препаратами для людей, які живуть з ВІЛ. Мапа дає можливість віднайти найближчий пункт тестування на ВІЛ або пункт видачі препаратів для лікування ВІЛ-інфекції, для проведення доконтактної та постконтактної профілактики найближче від поточного місця знаходження людини, дому, роботи, місця навчання. 🏥 Пункти що надають: - Тестування на ВІЛ - Усі ВІЛ послуги - Тестування та лікування ВІЛ (АРТ) - Тестування на ВІЛ та ДКП, PrEP - Тільки лікування ВІЛ (АРТ) - Лікування ВІЛ (АРТ) та ДКП, PrEP - Доконтактна профілактика ВІЛ (ДКП, PrEP) https://www.google.com/maps/d/viewer?mid=1nIfozgtdIs5SI34jrUK4muPbdmyAANM&femb=1&ll=47.09442530000001%2C30.773912299999985&z=18…